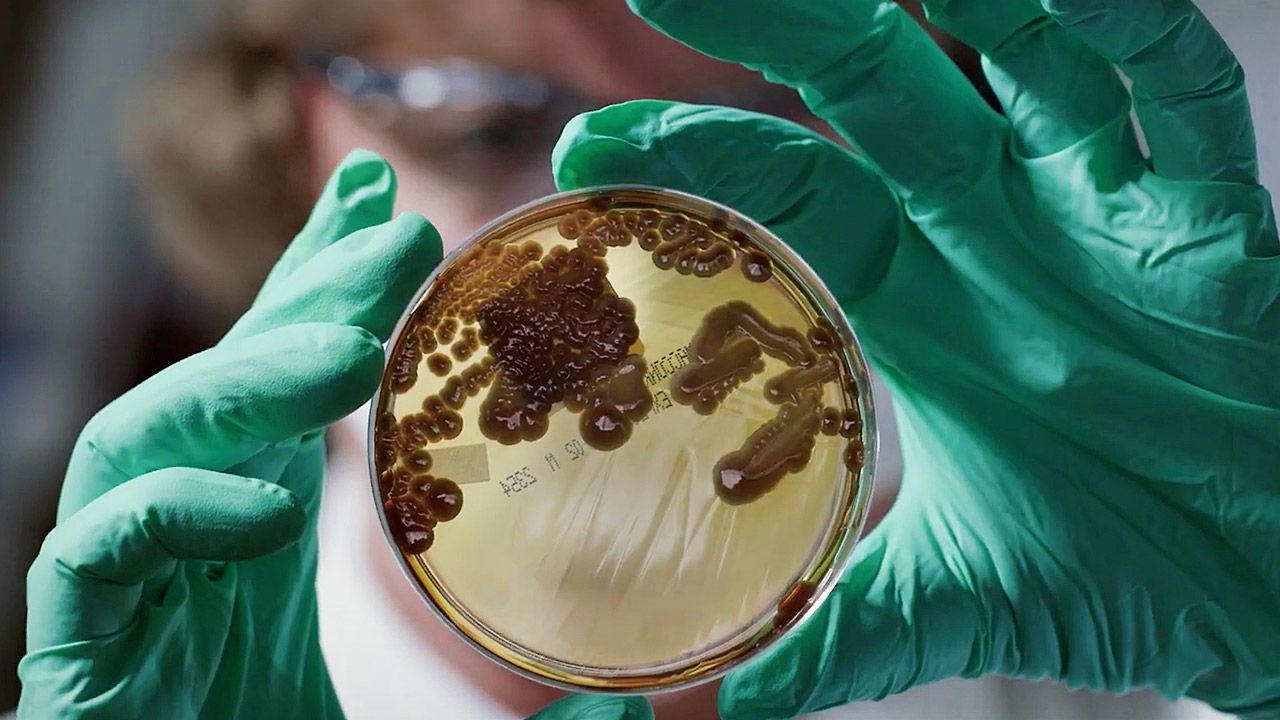

Resistance Fighters – Die globale Antibiotika-Krise
Jährlich sterben 700.000 Menschen durch multiresistente Keime – also Bakterien, die unempfindlich gegen Antibiotika sind. Die Resistance Fighters kämpfen dafür, dass wir noch lange etwas von der medizinischen Wunderwaffe haben. Die Doku begleitet Ärzte, Wissenschaftler, Patienten und Diplomaten.
Situationen
Bitte etwas BildungWeiterschauen
Melde Dich kostenlos bei Shelfd an, um alle Highlights im Feed freizuschalten

Hier entlang, falls Du schon einen Account hast.